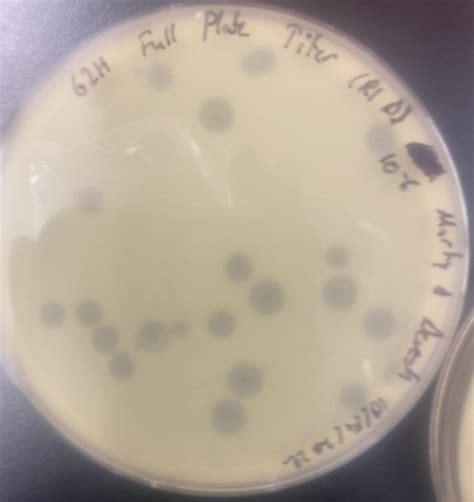

Microbacterium Minosphrime: Discoveries And Characteristics
Microbacterium Minosphrime: Discoveries and Characteristics
Let’s dive into the fascinating world of Microbacterium minosphrime ! This bacterium, part of the broader Microbacterium genus, has garnered attention in microbiology due to its unique characteristics and potential applications. In this article, we’ll explore everything from its discovery and classification to its morphology, habitat, biochemical properties, and ecological significance. Buckle up, microbiology enthusiasts; it’s going to be an enlightening journey!
Table of Contents
Discovery and Classification
The story of Microbacterium minosphrime begins with its isolation and identification. Typically, bacteria of this kind are discovered during environmental sampling or as part of broader microbiological surveys. The initial discovery often involves isolating the bacterium from a specific niche, followed by detailed characterization to determine its taxonomic placement. Speaking of taxonomy, Microbacterium belongs to the family Microbacteriaceae, which falls under the order Actinomycetales and the class Actinobacteria. These classifications are based on ribosomal RNA (rRNA) gene sequencing and comparative genomics, which help scientists understand the evolutionary relationships between different bacteria. The precise species name, minosphrime , would have been assigned based on specific differentiating characteristics that set it apart from other Microbacterium species. This could include unique metabolic capabilities, distinct genetic markers, or specific physiological traits. The scientists who first identified Microbacterium minosphrime would have meticulously documented these features, providing a comprehensive description that allows other researchers to accurately identify the bacterium. This foundational work is crucial because accurate classification is the cornerstone of understanding any organism’s role in its ecosystem and its potential applications in biotechnology or other fields. Furthermore, the classification process often involves comparing the newly discovered bacterium with known species using advanced molecular techniques, ensuring its place in the complex tree of life is accurately mapped. Think of it like detective work, but on a microscopic scale!
Morphology and Cultural Characteristics
When we talk about morphology, we’re essentially looking at the bacterium’s physical characteristics. Microbacterium minosphrime , like other members of its genus, is typically a Gram-positive bacterium. This means that when subjected to a Gram stain, the cell wall retains the crystal violet dye, appearing purple under a microscope. Gram-positive bacteria have a thick peptidoglycan layer in their cell walls, which is responsible for this staining reaction. Now, let’s get into the nitty-gritty: Microbacterium minosphrime cells are usually rod-shaped, though they can sometimes appear coccoid (spherical), especially under certain growth conditions or during different stages of their life cycle. Their size is generally in the range of 0.5 to 1.5 micrometers in width and 1 to 5 micrometers in length—tiny, indeed! But what about when you try to grow them in the lab? On agar plates, Microbacterium minosphrime colonies typically appear smooth, circular, and often have a creamy or slightly yellowish color. The exact color and texture can vary depending on the specific growth medium and incubation conditions. For instance, a nutrient-rich medium might result in faster growth and more vibrant colonies. Interestingly, Microbacterium species are known for their ability to grow under a wide range of conditions, including varying temperatures and pH levels. This adaptability is one of the reasons they can be found in diverse environments. When culturing Microbacterium minosphrime , microbiologists often use media like nutrient agar or tryptic soy agar, supplemented with specific nutrients to encourage optimal growth. Incubation temperatures usually range from 25°C to 37°C, but the optimal temperature can vary depending on the specific strain. Observing these cultural characteristics is vital for identifying and differentiating Microbacterium minosphrime from other bacteria in the lab. Each detail, from the colony’s color to its texture, provides clues that help microbiologists piece together the puzzle of this fascinating microorganism. These seemingly small details are actually significant fingerprints that aid in accurate identification and further study.
Habitat and Isolation
Microbacterium minosphrime , like other Microbacterium species, exhibits a remarkable ability to thrive in diverse environments. These bacteria are often isolated from soil, water, and even extreme environments. Their adaptability allows them to colonize various ecological niches, making them ubiquitous in nature. Soil is a common habitat for Microbacterium minosphrime . The bacterium can survive in both cultivated and uncultivated soils, participating in nutrient cycling and contributing to the overall health of the soil ecosystem. They’ve also been found in aquatic environments, including freshwater and marine habitats. In these settings, they may play a role in the decomposition of organic matter and the maintenance of water quality. What’s particularly interesting is the isolation of Microbacterium species from extreme environments. Some have been found in cold environments, such as glacial ice and permafrost, while others have been isolated from hot springs and desert soils. These extremophilic Microbacterium species have adapted to survive under harsh conditions, showcasing their resilience and metabolic versatility. Isolating Microbacterium minosphrime from environmental samples typically involves a series of microbiological techniques. First, samples are collected from the target environment (e.g., soil, water). Then, the samples are serially diluted and plated onto selective or non-selective agar media. Selective media contain specific compounds that inhibit the growth of other microorganisms while allowing Microbacterium minosphrime to grow. After incubation, colonies with the characteristic morphology of Microbacterium are selected for further analysis. This often involves Gram staining, biochemical testing, and molecular identification techniques, such as 16S rRNA gene sequencing. The ability of Microbacterium minosphrime to colonize diverse habitats underscores its ecological importance. Whether it’s breaking down complex organic compounds in the soil or surviving in extreme temperatures, this bacterium plays a role in maintaining the balance of its environment. Understanding its habitat preferences and isolation techniques is crucial for studying its ecological functions and potential applications.
Biochemical Properties
Let’s talk about what Microbacterium minosphrime can do on a biochemical level. Understanding a bacterium’s biochemical properties is crucial for identifying it and figuring out its metabolic capabilities. These properties are determined through a series of tests that assess the bacterium’s ability to utilize different substrates, produce specific enzymes, and tolerate various chemical conditions. Microbacterium minosphrime , like other members of its genus, exhibits a range of biochemical activities. One common test is the catalase test, which determines whether the bacterium can produce the enzyme catalase. Catalase breaks down hydrogen peroxide into water and oxygen, protecting the bacterium from the toxic effects of hydrogen peroxide. Microbacterium species are typically catalase-positive, indicating that they can produce this enzyme. Another important test is the oxidase test, which assesses the presence of cytochrome c oxidase, an enzyme involved in the electron transport chain. The results of this test can vary among Microbacterium species, but many are oxidase-positive. Carbohydrate utilization tests are also commonly performed to determine which sugars the bacterium can ferment. These tests involve inoculating the bacterium into media containing different carbohydrates (e.g., glucose, lactose, sucrose) and observing whether acid or gas is produced as a result of fermentation. Microbacterium minosphrime ’s carbohydrate utilization profile can provide valuable clues for its identification. In addition to these tests, other biochemical assays can be used to characterize Microbacterium minosphrime . These include tests for nitrate reduction, gelatin hydrolysis, and the production of specific enzymes like urease and amylase. The results of these tests help paint a comprehensive picture of the bacterium’s metabolic capabilities. Why is all this important? Well, knowing the biochemical properties of Microbacterium minosphrime not only helps in its identification but also provides insights into its ecological role and potential applications. For example, its ability to degrade certain compounds could make it useful in bioremediation, while its enzymatic activities could be harnessed for industrial processes. In short, delving into the biochemical properties of this bacterium opens up a world of possibilities for understanding and utilizing its capabilities.
Ecological Significance
The ecological significance of Microbacterium minosphrime is an area of growing interest, as scientists seek to understand the roles these bacteria play in various ecosystems. Their widespread presence in soil and water suggests they are involved in key processes such as nutrient cycling and the degradation of organic matter. In soil, Microbacterium minosphrime can contribute to the breakdown of complex organic compounds, releasing nutrients that are essential for plant growth. This process, known as decomposition, is vital for maintaining soil fertility and supporting healthy plant communities. These bacteria can also participate in the nitrogen cycle, converting atmospheric nitrogen into forms that plants can use. Their presence in aquatic environments indicates they may be involved in the degradation of pollutants and the maintenance of water quality. Some Microbacterium species have been shown to degrade hydrocarbons and other toxic compounds, making them potentially useful in bioremediation efforts. Furthermore, the ability of Microbacterium minosphrime to colonize extreme environments suggests they may play a role in the functioning of these unique ecosystems. For example, in cold environments, they may contribute to the decomposition of organic matter and the cycling of nutrients, even under harsh conditions. Their presence in these environments underscores their resilience and adaptability, highlighting their importance in maintaining ecological balance. Studying the ecological interactions of Microbacterium minosphrime can provide insights into the complex relationships between microorganisms and their environment. Understanding how these bacteria interact with other organisms, such as plants, fungi, and other bacteria, is crucial for comprehending their role in the ecosystem. This knowledge can be used to develop strategies for managing and restoring ecosystems, as well as for harnessing the beneficial activities of Microbacterium minosphrime for environmental applications. Overall, the ecological significance of Microbacterium minosphrime lies in its ability to participate in key ecological processes, contribute to nutrient cycling, and help maintain the health and stability of various ecosystems. As research in this area continues, we are likely to uncover even more about the important roles these bacteria play in the environment.
Potential Applications
The potential applications of Microbacterium minosphrime are vast and varied, spanning fields such as biotechnology, bioremediation, and agriculture. Given its diverse metabolic capabilities and adaptability, this bacterium holds promise for a range of innovative uses. In biotechnology, Microbacterium minosphrime can be utilized for the production of enzymes, biopolymers, and other valuable compounds. Its ability to grow under a wide range of conditions makes it an attractive candidate for industrial fermentation processes. For example, it could be engineered to produce specific enzymes for use in the food, pharmaceutical, or textile industries. In bioremediation, Microbacterium minosphrime has the potential to degrade pollutants and clean up contaminated environments. Some strains have been shown to degrade hydrocarbons, pesticides, and other toxic compounds, making them useful for removing these substances from soil and water. Its ability to thrive in diverse environments, including extreme conditions, enhances its suitability for bioremediation applications. In agriculture, Microbacterium minosphrime can be used to promote plant growth and enhance crop yields. Some strains have been shown to produce plant growth-promoting substances, such as phytohormones, which can stimulate root development and increase nutrient uptake. They can also help protect plants from pathogens by producing antimicrobial compounds or by competing with harmful microorganisms in the soil. Furthermore, Microbacterium minosphrime can be used in bioaugmentation strategies, where it is added to the soil to enhance its fertility and improve plant health. The application of Microbacterium minosphrime in these various fields requires careful optimization of growth conditions and metabolic activities. Researchers are actively exploring ways to enhance its performance through genetic engineering and other techniques. Understanding its specific metabolic pathways and regulatory mechanisms is crucial for maximizing its potential in these applications. Overall, the potential applications of Microbacterium minosphrime are diverse and promising. As research in this area continues, we are likely to see even more innovative uses for this versatile bacterium, contributing to advancements in biotechnology, environmental science, and agriculture. Guys, the future looks bright for this tiny but mighty microbe!
Conclusion
In conclusion, Microbacterium minosphrime is a fascinating bacterium with a wide range of characteristics that make it an important subject of study in microbiology. From its discovery and classification to its morphology, habitat, biochemical properties, ecological significance, and potential applications, Microbacterium minosphrime showcases the diversity and adaptability of the microbial world. Its ability to thrive in diverse environments, participate in key ecological processes, and offer potential solutions for various industrial and environmental challenges makes it a valuable resource for scientific research and technological innovation. As we continue to explore the microbial world, understanding the roles and capabilities of bacteria like Microbacterium minosphrime is crucial for advancing our knowledge of ecology, biotechnology, and human health. Further research into its genetic makeup, metabolic pathways, and interactions with other organisms will undoubtedly reveal even more about the potential of this versatile bacterium. So, let’s keep digging deeper into the microscopic universe and unlock the secrets that microbes like Microbacterium minosphrime hold. Who knows what amazing discoveries await us!